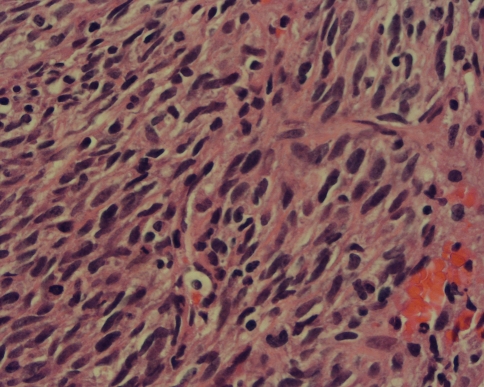
Fig. 6

History and Physical Examination
An 8-week-old girl presented with the chief complaint of a rapidly enlarging soft tissue mass located in the right shoulder/upper arm region. According to the parents, the mass was present at birth. Initially, this was thought to be a hematoma and observation was recommended. From the day of discharge (2 days postpartum) to presentation in clinic (at 8 weeks), the mass had enlarged rapidly, out of proportion relative to the child’s growth (Figs. 1, 2).
Fig. 1A–B.
The photographs show the (A) anterior and (B) posterior gross appearance of the mass 2 days postnatal. The mass involves the shoulder arc and extends to the distal third of the arm.
Fig. 2A–B.
(A) Anterior and (B) lateral clinical images obtained 8 weeks postnatal before biopsy are shown. Substantial growth of the mass is evident, with extension into the axillary region. Also noted is the markedly increased vascularity in the affected area.
This was the firstborn child, product of a naturally conceived, full-term pregnancy with an uncomplicated vaginal delivery. There was adequate prenatal care, but the last ultrasound was performed at 20 weeks of gestation, and there was no prenatal diagnosis of a mass. Family history was noncontributory and the child was otherwise healthy.
On physical examination, the child was a well-developed, well-nourished 8-week-old girl in no acute distress. There was an obvious, large mass involving the entire upper arm and shoulder girdle, extending distally just proximal to the elbow and medially into the axillary region. The mass had a moderately firm consistency; there were areas of fluctuance, most notably in the superolateral region. There was no apparent pain on palpation. The mass was nonpulsatile and nonmobile, and the overlying skin was distended with increased vascularity. She had full passive and active range of motion (ROM) of the shoulder and elbow. The distal neurovascular examination was normal. The remainder of the examination was unremarkable.
Laboratory studies, including a basic metabolic panel and a complete blood count with differential, showed no abnormalities. Plain radiographs (Fig. 3) and MRI scans (Fig. 4) were obtained before further workup.
Fig. 3.
An AP radiograph of the right shoulder shows a large soft tissue mass in the lateral aspect of the upper arm. There is periosteal bone reaction to the mass, with remodeling and new bone formation appearing as a result of a pressure phenomenon from the tumor against the bone.
Fig. 4A–D.
(A) An axial T1-weighted image shows a large soft tissue mass involving all quadrants of the arm, without bony invasion, and an (B) axial fat-saturated T2-weighted image shows heterogeneous enhancement with gadolinium. (C) A coronal T-1 weighted image shows the soft tissue mass involving all quadrants of the arm, and the (D) fat-saturated T2-weighted image shows heterogeneous enhancement with gadolinium. The lateral aspect of the mass contains a substantial cystic component; a fluid-fluid level (B, arrowhead) is seen. Deep tubular structures of variable signal intensity, labeled with black plus-signs (+) may represent dilated, low-flow venous components. The humeral head is annotated with a white asterisk (*).
Given the size and appearance of the mass, malignancy was a concern; a needle biopsy was performed, followed by further screening workup. No other lesions were seen on the bone scan or CT of the chest, abdomen, and pelvis.
Based on the history, physical examination, laboratory studies, and imaging studies, what is the differential diagnosis at this point?
Imaging Interpretation
Plain radiographs (Fig. 3) showed a large soft tissue mass causing secondary humerus remodeling and slight valgus angulation but with no definitive bone invasion or scalloping. MRI showed this large lesion (Fig. 4) better. It was a well-circumscribed, discrete, heterogeneous mass, relatively isointense to muscle on T1-weighted imaging, with variable areas of moderately increased signal on T2-weighted images. In the areas of solid tumor, cystic fluid-fluid levels and tubular structures with varying signal intensity also were evident. The mass extended medially into the axilla and from the superolateral aspect of the arm to the distal third of the triceps compartment. There was no direct invasion of the bone or periosteum.
Differential Diagnosis
Infantile hemangioma
Vascular malformation
Infantile myofibromatosis
Congenital fibrosarcoma
Rhabdomyosarcoma
The patient underwent needle biopsy of the lesion and histologic studies were performed (Figs. 5, 6).
Fig. 5.
A low-power view shows a spindle cell tumor arranged in a herringbone-type pattern with focal areas of hemorrhage (Stain, hematoxylin and eosin; magnification, ×10).
Fig. 6.
A high-power view shows atypical plump oval to spindle cells with moderate eosinophilic fibrillary cytoplasm. Isolated mononuclear small lymphocytes also are present (Stain, hematoxylin and eosin; magnification, ×40).
Based on the history, physical examination, laboratory studies, imaging studies, and histologic picture, what is the diagnosis and how should this lesion be treated?
Histology Interpretation
The tumor was comprised of plump atypical spindle and ovoid cells arranged in a fascicular or herringbone-type pattern (Fig. 5). The cells appeared immature with minimal to mild eosinophilic fibrillary cytoplasm. There was minimal pleomorphism and frequent mitoses (10–11 per 5 high power fields.) The mass also contained scattered amounts of chronic mononuclear inflammatory cells (Fig. 6). Focal areas of hemorrhage and necrosis also were identified. Immunohistochemical staining for CD34, CD31, Factor VIII, HHF-35, SMA, desmin, S-100, and keratin were all negative. CD99 was positive. Ki-67 (proliferative index) was approximately 20% to 30%. FISH analysis for FKHR on 13q14, SYT on 18q11.2, and EWSR on 22q12 were negative. Reverse-transcription polymerase chain reaction (RT-PCR) was positive for ETV6/NTRK3 t(12;15)(q13;q25) translocation.
Diagnosis
Congenital or infantile fibrosarcoma
Discussion and Treatment
The differential diagnosis for a soft tissue mass in the extremity of an infant is broad, and includes benign and malignant processes, and congenital anomalies.
Hemangiomas are the most common tumor of infancy, occurring in 4% to 10% of infants [2, 15, 40], and approximately 15% of these lesions involve the extremities. Congenital hemangiomas differ as they are fully grown by birth and do not have the characteristic postnatal rapid growth phase, tending to involute after 1 year [12]. Histologically, hemangiomas contain plump epithelial cells and lobules of benign-appearing capillaries, and have markers for vascular tumors [2, 15]. Vascular malformations can have similar clinical presentation at birth, but do not have the rapid growth pattern. MRI shows vascular channels and structures; lesions contain abnormal arterial, venous and lymphatic elements. Histologically these malformations are characterized by normal, mature vascular endothelium [26, 29].
Infantile myofibromatosis is a benign spindle cell tumor [39] characteristically appearing within the first 2 years of life, but with as many as 60% present at birth [7, 35, 39]. Although MRI findings overlap with congenital fibrosarcoma, the vascular elements and cystic structures seen in our patient are not typical for myofibromatosis [21, 35]. Histologically, myofibromatosis may show frequent mitoses and a highly cellular spindle-cell proliferation, but its cytologic features are overall benign. Furthermore, it has a characteristic arrangement of plump spindle cells and immature-appearing cells surrounding thin, irregularly branching blood vessels [1, 7, 28] and positive SMA staining. Finally, as radiographic and histologic features of congenital fibrosarcoma and myofibromatosis often overlap, RT-PCR identification of the ETV6-NTRK3 fusion protein was critical for differentiation between the two entities [1].
Rhabdomyosarcoma is the most common soft tissue sarcoma of childhood [11, 18], with approximately 10% occurring in infants, but fewer than 2% are congenital [11, 13, 31]. MRI features are nonspecific and similar to congenital fibrosarcoma [24, 25], therefore the differentiation has to be made at a histologic level. Malignant rhabdomyoblasts [38] and immunohistochemical markers (SMA and desmin) [19] are present in rhabdomyosarcoma but not in congenital fibrosarcoma.
Congenital or infantile fibrosarcoma is a rare fibroblastic tumor, but is the most common soft tissue sarcoma in patients younger than 1 year, with 1/3 of cases present at birth [8, 9, 18, 36]. Extremities are the most common location, whereas truncal lesions carry a poorer prognosis [4, 32]. Although histologically identical to the adult-type fibrosarcoma, there are distinct cytogenetic and clinical characteristics [20]. Moreover, unlike its adult counterpart, congenital fibrosarcoma metastasizes in less than 10% of patients and carries a good prognosis, despite its ominous histologic appearance and locally aggressive behavior [3, 4, 14, 36]. Five- and 10-year survival rates are approximately 80% to 90% [6, 27, 30, 32], and amputation rates appear to be declining [3, 8, 30]
MRI findings are generally nonspecific, and show a well-circumscribed, heterogeneous mass, with vascular elements, areas of necrosis, and hemorrhage. The mass is typically isointense to muscle on T1-weighted images and heterogeneously hyperintense on T2-weighted images; gadolinium enhancement is variable [5, 24]. Although the lung is the most common site of metastases, congenital fibrosarcoma can metastasize to bone [3, 36], with technetium-99 bone scan being useful for detection of these metastases.
Microscopically, congenital fibrosarcoma is a hypercellular, hyperchromatic, anaplastic spindle cells tumor arranged in a herringbone pattern, with frequent mitoses, necrosis, and hemorrhage [4]. Immunohistochemistry and cytogenetics often are needed, and show negative staining for SMA, S-100, desmin, CD31, and CD34 [19]. Congenital fibrosarcoma is characterized by a recurrent t(12;15)(p13;q25) rearrangement, producing the ETV6 (TEL):NTRK3 (neurotrophin-3 receptor) fusion protein identified by RT-PCR [20, 34] and not expressed by the adult-type fibrosarcoma [33].
The treatment for congenital fibrosarcoma is multimodal, but the mainstay is surgical excision. Although the adoption of limb-salvage techniques has been proposed, the overall amputation rate for congenital fibrosarcoma still approaches 50% [3, 8, 30], and it is not always clear which patients will have postsurgical local recurrence. Chemoresponsiveness of congenital fibrosarcoma is unclear [6, 30], however neoadjuvant chemotherapy may be used, in an attempt to decrease tumor size and reduce the surgical morbidity. Chemotherapy also has been used for unresectable lesions [3, 16, 17, 22, 27, 37]. The most common regimen used combines vincristine, actinomycin D, and cyclophosphamide (VAC) [6, 30]; its side effect is well established and is tolerable in infants [10, 22, 23].
In our patient, neoadjuvant chemotherapy with three courses of VAC and one course exchanging actinomycin D for Adriamycin® (Pharmacia, Kalamazoo, MI) was used in an attempt to reduce the size of the tumor. Except for intratumoral bleeding, there was no significant change. Limb-salvage surgery was performed with microdissection of the brachial plexus and wide excision of the mass with free margins. Postoperative chemotherapy was not administered, owing to the poor response (< 80% necrosis) and negative margins. At 2 years followup, the patient is continuously free of disease, and has recovered full ROM of her shoulder and elbow with no functional deficit.
We present the case of a patient with congenital fibrosarcoma treated with a limb-salvage strategy using neoadjuvant chemotherapy and wide surgical excision. It is still unclear whether there are specific attributes of congenital fibrosarcoma that confer chemoresponsiveness; our patient had some tumor necrosis without a reduction in tumor size. Nonetheless, given some successes reported in the literature, it is not unreasonable to include neoadjuvant chemotherapy in the overall treatment armamentarium when considering limb-salvage strategies. As we progress toward better comprehension of tumor characterization, behavior and treatment response patterns, we move away from highly morbid amputations as the mainstay of treatment for congenital fibrosarcoma.
Acknowledgment
We thank Dr. Milan Stevanovic for microsurgery expertise and Dr. William A. May for contributions to the discussion and management regarding chemotherapy for this patient.
Footnotes
Each author certifies that he or she has no commercial associations (eg, consultancies, stock ownership, equity interest, patent/licensing arrangements, etc) that might pose a conflict of interest in connection with the submitted article.
Each author confirms that his or her institution has approved the reporting of this case report and that all investigations were conducted in conformity with ethical principles of research.
This work was performed at Children’s Hospital of Los Angeles.
References
- 1.Alaggio R, Barisani D, Ninfo V, Rosolen A, Coffin CM. Morphologic overlap between infantile myofibromatosis and infantile fibrosarcoma: a pitfall in diagnosis. Pediatr Dev Pathol. 2008;11:355–362. doi: 10.2350/07-09-0355.1. [DOI] [PubMed] [Google Scholar]
- 2.Berenguer B, Mulliken JB, Enjolras O, Boon LM, Wassef M, Josset P, Burrows PE, Perez-Atayde AR, Kozakewich HP. Rapidly involuting congenital hemangioma: clinical and histopathologic features. Pediatr Dev Pathol. 2003;6:495–510. doi: 10.1007/s10024-003-2134-6. [DOI] [PubMed] [Google Scholar]
- 3.Blocker S, Koenig J, Ternberg J. Congenital fibrosarcoma. J Pediatr Surg. 1987;22:665–670. doi: 10.1016/S0022-3468(87)80123-9. [DOI] [PubMed] [Google Scholar]
- 4.Bourgeois JM, Knezevich SR, Mathers JA, Sorensen PHB. Molecular detection of the ETV6-NTRK3 gene fusion differentiates congenital fibrosarcoma from other childhood spindle cell tumors. Am J Surg Pathol. 2000;24:937–946. doi: 10.1097/00000478-200007000-00005. [DOI] [PubMed] [Google Scholar]
- 5.Canale S, Vanel D, Couanet D, Patte C, Caramella C, Dromain C. Infantile fibrosarcoma: magnetic resonance imaging findings in six cases. Eur J Radiol. 2009;72:30–37. doi: 10.1016/j.ejrad.2009.05.036. [DOI] [PubMed] [Google Scholar]
- 6.Cecchetto G, Carli M, Alaggio R, Dall’Igna P, Bisogno G, Scarzello G, Zanetti I, Durante G, Inserra A, Siracusa F, Guglielmi M, Italian Cooperative Group Fibrosarcoma in pediatric patients: results of the Italian Cooperative Group studies (1979–1995) J Surg Oncol. 2001;78:225–231. doi: 10.1002/jso.1157. [DOI] [PubMed] [Google Scholar]
- 7.Chung EB, Enzinger FM. Infantile myofibromatosis. Cancer. 1981;48:1807–1818. doi: 10.1002/1097-0142(19811015)48:8<1807::AID-CNCR2820480818>3.0.CO;2-G. [DOI] [PubMed] [Google Scholar]
- 8.Coffin CM, Dehner LP. Soft tissue tumors in the first year of life: a report of 190 cases. Pediatr Pathol. 1990;10:509–526. doi: 10.3109/15513819009067140. [DOI] [PubMed] [Google Scholar]
- 9.Coffin CM, Jaszcz W, O’Shea PA, Dehner LP. So-called congenital-infantile fibrosarcoma: does it exist and what is it? Pediatr Pathol. 1994;14:133–150. doi: 10.3109/15513819409022033. [DOI] [PubMed] [Google Scholar]
- 10.Crist WM, Anderson JR, Meza JL, Fryer C, Raney RB, Ruymann FB, Breneman J, Qualman SJ, Wiener E, Wharam M, Lobe T, Webber B, Maurer HM, Donaldson SS. Intergroup rhabdomyosarcoma study-IV: results for patients with nonmetastatic disease. J Clin Oncol. 2001;19:3091–3102. doi: 10.1200/JCO.2001.19.12.3091. [DOI] [PubMed] [Google Scholar]
- 11.Enzinger FM, Weiss SW. Fibrosarcoma. In: Weiss SW, Goldblum JR, editors. Enzinger and Weiss’s Soft Tissue Tumors. 4. St Louis, MO: Mosby Inc; 2001. pp. 409–441. [Google Scholar]
- 12.Ernemann U, Kramer U, Miller S, Bisdas S, Rebmann H, Brueuninger H, Zwick C, Hoffmann J. Current concepts in the classification: diagnosis and treatment of vascular anomilies. Eur J Radiol. 2010;75:2–11. doi: 10.1016/j.ejrad.2010.04.009. [DOI] [PubMed] [Google Scholar]
- 13.Ferrari A, Casanova M, Bisogno G, Zanetti I, Cecchetto G, DeBernardi B, Riccardi R, Tamaro P, Meazza C, Alaggio R, Ninfo V, Carli M, Italian Cooperative Group Rhabdomyosarcoma in infants younger than one year old: a report from the Italian Cooperative Group. Cancer. 2003;97:2597–2604. doi: 10.1002/cncr.11357. [DOI] [PubMed] [Google Scholar]
- 14.Fisher C. Fibromatosis and fibrosarcoma in infancy and childhood. Eur J Cancer. 1996;32A:2094–2100. doi: 10.1016/S0959-8049(96)00287-0. [DOI] [PubMed] [Google Scholar]
- 15.Goh SG, Calonje E. Cutaneous vascular tumours: an update. Histopathology. 2008;52:661–673. doi: 10.1111/j.1365-2559.2007.02924.x. [DOI] [PubMed] [Google Scholar]
- 16.Grier HE, Perez-Atayde AR, Weinstein HJ. Chemotherapy for inoperable infantile fibrosarcoma. Cancer. 1985;56:1507–1510. doi: 10.1002/1097-0142(19851001)56:7<1507::AID-CNCR2820560705>3.0.CO;2-7. [DOI] [PubMed] [Google Scholar]
- 17.Grohn ML, Borzi P, Mackay A, Suppiah R. Management of extensive congenital fibrosarcoma with preoperative chemotherapy. ANZ J Surg. 2004;74:919–921. doi: 10.1111/j.1445-1433.2004.03181.x. [DOI] [PubMed] [Google Scholar]
- 18.Gurney JG, Smith MA, Ross JA. Cancer Among Infants. In: Cancer Incidence and Survival Among Children and Adolescents: United States SEER Program 1975–1995. National Cancer Institute, Cancer Statistics Branch, SEER Program. Bethesda, MD: National Cancer Institute; 1999; NIH Pub. No. 99-4649.
- 19.Heim-Hall J, Yohe SL. Application of immunohistochemistry to soft tissue neoplasms. Arch Pathol Lab Med. 2008;132:476–489. doi: 10.5858/2008-132-476-AOITST. [DOI] [PubMed] [Google Scholar]
- 20.Knezevich SR, McFadden DE, Tao W, Lim JF, Sorensen PH. A novel ETV6-NTRK3 gene fusion in congenital fibrosarcoma. Nature Genet. 1998;18:184–187. doi: 10.1038/ng0298-184. [DOI] [PubMed] [Google Scholar]
- 21.Koujok K, Ruiz RE, Hernandez RJ. Myofibromatosis: imaging characteristics. Pediatr Radiol. 2005;35:374–380. doi: 10.1007/s00247-004-1357-7. [DOI] [PubMed] [Google Scholar]
- 22.Kurkchubasche AG, Halvorson EG, Forman EN, Terek RM, Ferguson WS. The role of preoperative chemotherapy in the treatment of infantile fibrosarcoma. J Pediatr Surg. 2000;35:880–883. doi: 10.1053/jpsu.2000.6871. [DOI] [PubMed] [Google Scholar]
- 23.Kynaston JA, Malcom AJ, Craft AW, Davies SM, Jones PH, King DJ, Mitchell CD, Oakhill A, Stiller CA. Chemotherapy in the management of infantile fibrosarcoma. Med Pediatr Oncol. 1993;21:488–493. doi: 10.1002/mpo.2950210706. [DOI] [PubMed] [Google Scholar]
- 24.Laffan EE, Ngan BY, Navarro OM. Pediatric soft-tissue tumors and pseudotumors: MR imaging features with pathologic correlation: Part 2: Tumors of fibroblastic/myofibroblastic, so-called fibrohistiocytic, muscular, lymphomatous, neurogenic, hair matrix and uncertain origin. Radiographics. 2009;29:e36. doi: 10.1148/rg.e36. [DOI] [PubMed] [Google Scholar]
- 25.Laor T. MR imaging of soft tissue tumors and tumor-like lesions. Pediatr Radiol. 2004;34:24–37. doi: 10.1007/s00247-003-1086-3. [DOI] [PubMed] [Google Scholar]
- 26.Lee BB. Critical issues in management of congenital vascular malformation. Ann Vasc Surg. 2004;18:380–392. doi: 10.1007/s10016-004-0020-y. [DOI] [PubMed] [Google Scholar]
- 27.Loh ML, Ahn P, Perez-Atayde AR, Gebhardt MC, Shamberger RC, Grier HE. Treatment of infantile fibrosarcoma with chemotherapy and surgery: results from the Dana-Farber Cancer Institute and Children’s Hospital, Boston. J Pediatr Hematol Oncol. 2002;24:722–726. doi: 10.1097/00043426-200212000-00008. [DOI] [PubMed] [Google Scholar]
- 28.Mentzel T, Calonje E, Nascimento AG, Fletcher CDM. Infantile hemangiopericytoma versus infantile myofibromatosis: study of a series suggesting a continuous spectrum of infantile myofibroblastic lesions. Am J Surg Pathol. 1994;18:922–930. doi: 10.1097/00000478-199409000-00007. [DOI] [PubMed] [Google Scholar]
- 29.Mulliken JB, Glowacki J. Hemangiomas and vascular malformations in infants and children: a classification based on endothelial characteristics. Plast Reconstr Surg. 1982;69:412–422. doi: 10.1097/00006534-198203000-00002. [DOI] [PubMed] [Google Scholar]
- 30.Orbach D, Rey A, Cecchetto C, Oberlin O, Casanova M, Thebaud E, Scopinaro M, Bisogno G, Carli M, Ferrari A. Infantile fibrosarcoma: management based on the European experience. J Clin Oncol. 2010;28:318–323. doi: 10.1200/JCO.2009.21.9972. [DOI] [PubMed] [Google Scholar]
- 31.Pastore G, Peris-Bonet R, Carli M, Martínez-García C, Sánchez de Toledo J, Steliarova-Foucher E. Childhood soft tissue sarcomas incidence and survival in European children (1978–1997): report from the Automated Childhood Cancer Information System project. Eur J Cancer. 2006;42:2136–2149. doi: 10.1016/j.ejca.2006.05.016. [DOI] [PubMed] [Google Scholar]
- 32.Pritchard DJ, Soule EH, Taylor WF, Ivins JC. Fibrosarcoma: a clinicopathologic and statistical study of 199 tumors of the soft tissues of the extremities and trunk. Cancer. 1974;33:888–897. doi: 10.1002/1097-0142(197403)33:3<888::AID-CNCR2820330339>3.0.CO;2-C. [DOI] [PubMed] [Google Scholar]
- 33.Sandberg AA, Bridge JA. Updates on the cytogenetics and molecular genetics of bone and soft tissue tumors: congenital (infantile) fibrosarcoma and mesoblastic nephroma. Cancer Genet Cytogenet. 2002;132:1–13. doi: 10.1016/S0165-4608(01)00528-3. [DOI] [PubMed] [Google Scholar]
- 34.Sheng WQ, Hisaoka M, Okamoto S, Tanaka A, Meis-Kindblom JM, Kindblom LG, Ishida T, Nojima T, Hashimoto H. Congenital-infantile fibrosarcoma: a clinicopathologic study of 10 cases and molecular detection of the ETV6-NTRK3 fusion transcripts using paraffin-embedded tissues. Am J Clin Pathol. 2001;115:348–355. doi: 10.1309/3H24-E7T7-V37G-AKKQ. [DOI] [PubMed] [Google Scholar]
- 35.Soper JR, Silva M. Infantile myofibromatosis: a radiologic review. Pediatr Radiol. 1993;23:189–194. doi: 10.1007/BF02013829. [DOI] [PubMed] [Google Scholar]
- 36.Soule EH, Pritchard DJ. Fibrosarcoma in infants and children: a review of 110 cases. Cancer. 1977;40:1711–1721. doi: 10.1002/1097-0142(197710)40:4<1711::AID-CNCR2820400447>3.0.CO;2-9. [DOI] [PubMed] [Google Scholar]
- 37.Surico G, Muggeo P, Daniele RM, Novielli C, Rigillo N, Minervini C. Letters to the Editor. Chemotherapy alone for the treatment of congenital fibrosarcoma: is surgery always needed? Med Pediatr Oncol. 2003;40:268–270. doi: 10.1002/mpo.10150. [DOI] [PubMed] [Google Scholar]
- 38.Wexler LH, Helman LJ. Pediatric soft tissue sarcomas. CA Cancer J Clin. 1994;44:211–247. doi: 10.3322/canjclin.44.4.211. [DOI] [PubMed] [Google Scholar]
- 39.Wiswell TE, Davis J, Cunningham BE, Solenberger R, Thomas PJ. Infantile myofibromatosis: the most common fibrous tumor of infancy. J Pediatr Surg. 1988;23:315–318. doi: 10.1016/S0022-3468(88)80196-9. [DOI] [PubMed] [Google Scholar]
- 40.Yan AC, Chamlin SL, Liang MG, Hoffman B, Attiyeh EF, Chang B, Honig PJ. Congenital infantile fibrosarcoma: a masquerader of ulcerated hemangioma. Pediatr Dermatol. 2006;23:330–334. doi: 10.1111/j.1525-1470.2006.00257.x. [DOI] [PubMed] [Google Scholar]